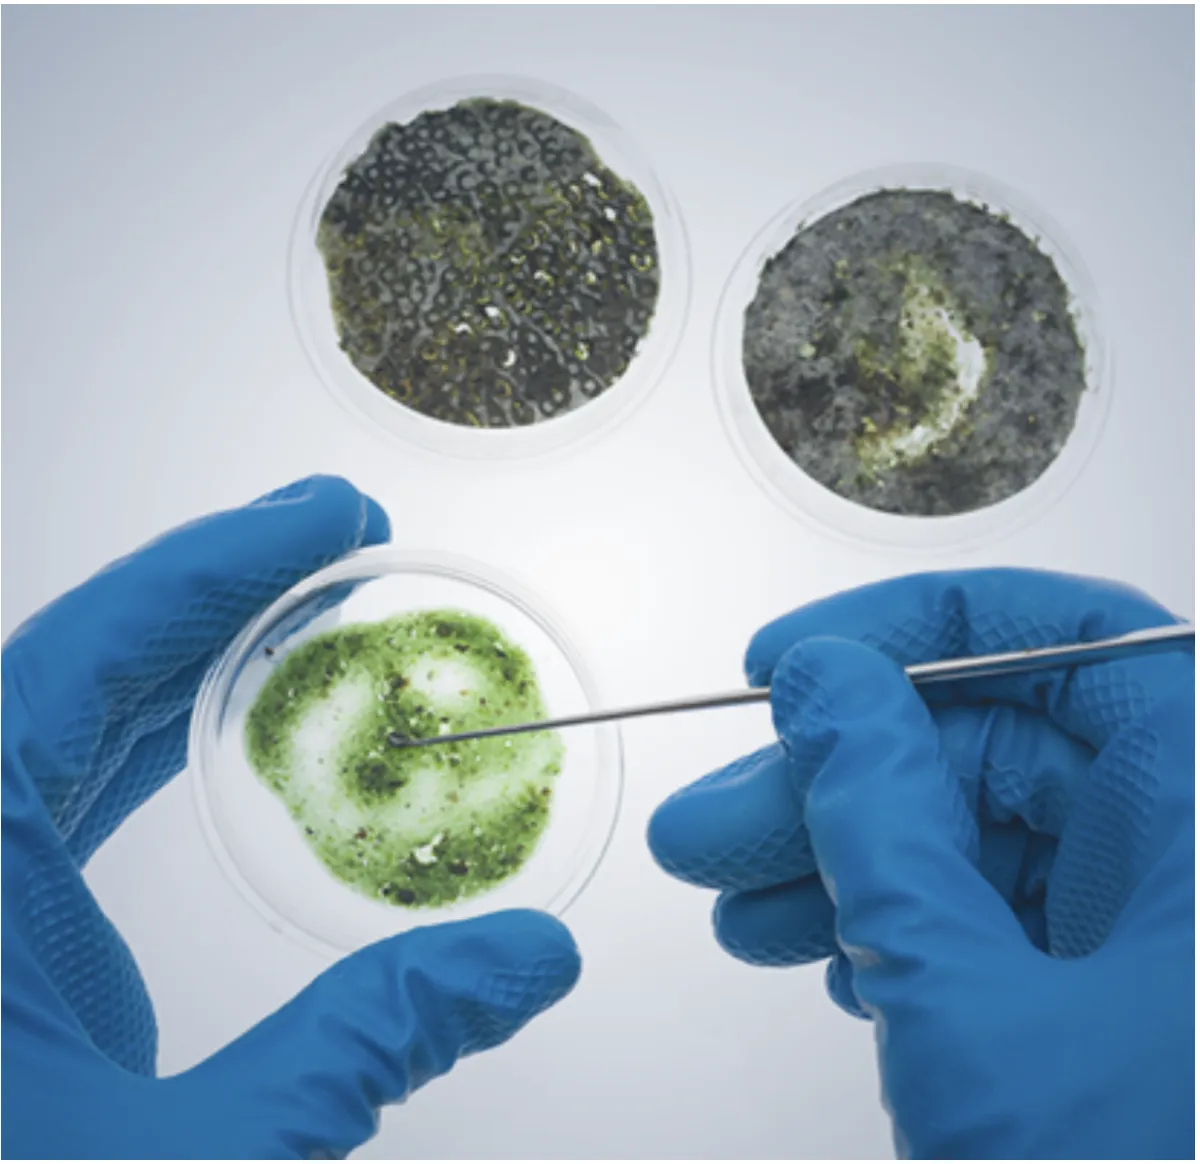

PROFESSIONAL MOLD INSPECTION IN PANAMA CITY AND 30A, FLORIDA
ADHERING TO THE HIGHST INDUSTRY STANDARDS
ADHERING TO THE HIGHST INDUSTRY STANDARDS
PROFESSIONAL MOLD INSPECTION IN PANAMA CITY
Get high-result mold inspection services
Get high-result mold inspection services
What is Mold?
Mold is a type of fungus that grows in our natural environment when exposed to excess water. Mold spores–tiny microscopic seeds–can be found virtually everywhere, including in homes.
They waft through indoor and outdoor air continually, growing on home and building materials and furnishings. When mold spores land on a damp spot indoors, they may begin to grow and digest the material.
When excessive moisture or water accumulates indoors, mold growth will often occur, particularly if the moisture problem remains undiscovered or un-addressed. The key to preventing mold growth is to control moisture intrusion.

Mold Inspection Services in Panama City Beach, Santa Rosa, and Destin, Florida
What is Mold?
Mold is a type of fungus that grows in our natural environment when exposed to excess water. Mold spores–tiny microscopic seeds–can be found virtually everywhere, including in homes.
They waft through indoor and outdoor air continually, growing on home and building materials and furnishings. When mold spores land on a damp spot indoors, they may begin to grow and digest the material.
When excessive moisture or water accumulates indoors, mold growth will often occur, particularly if the moisture problem remains undiscovered or un-addressed. The key to preventing mold growth is to control moisture intrusion.
Signs of Mold
Visual Mold
Strong, Musty Odor
Moisture Intrusion
High Humidity Levels
Air Quality Test

Mold is particularly dangerous because isn't always visible when it's present. The only way to ensure a home is mold-free is to test for it.
Mold Surface Swab

Collecting a surface sample helps identifying the type and concentration of mold fragments.
Mold/Water Damage Assessment

It's a complete evaluation (including testing) on water damage and mold. It is usually done to file a water damage claim or to have a clear picture where mold is growing.
Our Pricing
The cost of mold inspection may vary from one company to another. However, it’s important to inform yourself about a provider’s pricing before hiring them. Keep in mind that low prices may often include hidden costs. It’s always best to go with a company that offers a transparent pricing model.
With us, you can count on absolute honesty and transparency. Our competitive fees are disclosed on our website and fully adjusted to specific types and sizes of properties. We aim at delivering superb services at cost-effective rates that guarantee value for money. Let us prove it!
The Air Quality Test/Surface Swab costs $350 for homes up to 2400 square feet, which includes 1 exterior sample (used to establish a baseline) and 2 indoor samples. Every additional 1,000 square feet requires one more sample (+$100).The mold assessor will determine the exact location. If mold has already been found, we will take 1 air sample and 1 surface swab to determine the type of mold.
A Mold Assessment (or Water Damage Assessment), with Remediation Protocol (where applicable) costs $495 for homes up to 2400 square feet. It includes air quality test/surface swab, a mold inspection, and infrared thermal imaging scan. If mold and/or water damage are found, a remediation protocol will be provided.
A Post Remediation Verification costs $350 for homes up to 2400 square feet. It includes testing and a clearance letter after the remediation has been completed.
Here at Elite Property Inspectors, we offer superior mold inspection services that always deliver. A baseline mold inspection is essential for maintaining a healthy, clean home with high indoor air quality, and it comes easy with us. Our mold inspection services bring invaluable benefits to homeowners.
Is a mold inspection necessary?
Here are some of the most important reasons why you should consider scheduling our meticulous Elite Property Inspectors home and mold inspection service:
For homebuyers in Panama City who are concerned about mold when purchasing a new home. Mold testing offers peace of mind in such a big decision.
For verified mold assessment and verification of the need for remediation. Many insurance companies will not authorize mold remediation without demonstrated scientific testing.
To create the parameters for mold remediation. A testing company is usually consulted to help define the boundaries of an affected area for the remediators.
To identify the types of mold that are present in a home environment. Often residents are curious if a mold presence could relate to medical symptoms they may be experiencing.
To find “hidden mold” or mold growth that may not be visible within the home’s immediate visual structure, but may be a cause for concern as a result of water leakage or the development of a moldy odor.
In support of a legal case where objective scientific evidence is needed to support legal action.
Which Service Do I Need?
I don't see mold and want to know if it is present, hiding somewhere.
The Air Quality Test/Surface Swab costs $350 for homes up to 2400 square feet, which includes 1 exterior sample (used to establish a baseline) and 2 indoor samples. Every additional 1,000 square feet requires one more sample (+$100).
I see surface mold.
We can do testing only to see the type and if it has spread in your indoor air. Or, we can do a full mold assessments which includes testing, inspection with infrared scan, and a written report that you can use to file a claim and/or a remediation plan.
I have water damage.
Mold/Water Damage Assessment. It includes mold testing, inspection with infrared scan, a written document that includes a remediation plan.
Mold remediation has been completed and want to know if mold has been completely removed.
Post Remediation Verification.
Title or Question
Describe the item or answer the question so that site visitors who are interested get more information. You can emphasize this text with bullets, italics or bold, and add links.
Title or Question
Describe the item or answer the question so that site visitors who are interested get more information. You can emphasize this text with bullets, italics or bold, and add links.
Common Questions and Answers
What to expect from a mold inspection?
Our professional mold inspectors use a multistep process to determine whether there is any kind of mold hiding in your home. Our process typically includes:
A preliminary visual inspection. This is performed in each room to look for signs of microbial activity, water damage, moisture intrusion, dank odor, etc. Suspicious areas may require readings from a moisture meter or a thermal imaging camera to further detect moisture within wall cavities.
The visual inspection. This step helps identify which rooms require an air sample reading alongside an outdoor control sample to determine if elevated conditions exist. Further sampling and mold assessment may be recommended in order to determine the source of the problem and its spread.
The resulting report. A detailed report of your home inspection will come directly from the lab and include the types of molds found in your home, how your levels compare to “normal” levels, the glossary of mold, and a list of probable symptoms resulting from exposure. This is a legal and verifiable document.
The post-inspection process. Our certified mold professionals will guide you through this step. They will go over the report with you and offer advice on how to best move forward in the mold remediation process. The mold removal process should be handled expertly as it can be more dangerous than the mold’s initial presence.
To begin the mold inspection process, clients must first disclose their reasons or concerns for warranting the services of our certified mold inspectors. Our team will come at your convenience to conduct an exhaustive inspection of your property using a high-tech mold testing kit. Rest assured we never cut corners when checking for mold, but offer nothing but excellence to our clients!
How long does a mold inspection take?
In general, a mold inspection may last around an hour. However, exactly how long the inspection of your home will last will depend on a number of factors:
Whether the mold is visible or hidden
The size of your home
The afflicted area
As one of the most reputable mold inspection companies across the Panama City area, we deliver prompt, time-efficient services. Our team consists of the leading specialists in the field who boast excellent records, so they know exactly what and where to look. With us, you can count on stellar mold inspection and testing that won’t disrupt your daily life. Let’s bring back freshness to your home!
How do you prepare for a mold inspection?
After scheduling the services of experienced mold inspectors, you should take a few steps to prepare for your appointment:
Isolate the afflicted area by covering it with a plastic or sealing the room off by covering the door.
Don’t clean it yourself because you don’t have the necessary equipment and experience.
Make sure the pros can access the area with mold by clearing out any clutter or unnecessary items.
Book our mold inspection services in Panama City and let us handle the rest. We guarantee to be thorough and efficient, delivering our service to the highest industry standards. Our team members are InterNACHI-certified, so there’s no doubt they’ll do an above-par job. Reach out to us if you want to learn more about proper preparation before we come to your home for a professional inspection.
How can I prevent mold in my house?
By taking precautions and implementing best practices, you can prevent mold from growing and spreading in your home. However, if you discover any afflicted area, you may need to schedule professional mold removal and remediation services. Either way, here’s what you should keep in mind:
Address moisture issues. Familiarize yourself with the possibilities for direct water intrusion due to structural leakage, plumbing problems, or foundational issues. An excess of humidity can also lead to increased condensation and mold growth and development.
Keep your home clean. A well-kept indoor environment is instrumental in preventing mold growth. Wiping surfaces with household cleaners such as bleach, borax, or vinegar can be helpful in treating and killing mold and its spores. Remember to avoid mixing solutions before reading the safety instructions to avoid intoxication.
Ensure adequate airflow and ventilation. People often forget that an air conditioning unit also doubles as a building’s dehumidifier. Well circulated airflow and ventilation help prevent mold infestation risks by allowing water and condensation to escape. Remember to regularly check and clean your kitchen vent hood and HVAC filters.
Mind the dark. Mold loves to grow in dark damp areas, so avoid piles of wet laundry and open your blinds and shades regularly. Ultraviolet light kills mold.
However, keep in mind that mold remediation requires the intervention of licensed, trained professionals. So, we recommend you do not try to address the problem yourself, for your health and safety. Let us advise you on how to approach and resolve this problem!
Panama City's #1 experts in home and mold inspection services
Here at Elite Property Inspectors, our team specializes in a range of home-related services, including expert mold inspection and prevention. We will check every nook and cranny of your home and suggest effective prevention and removal solutions.
Furthermore, we have the equipment and experience needed to detect even hidden mold in your home. Our qualified and seasoned specialists can also advise you on the best home maintenance practices that will help you prevent more serious damage or future problems. Bid mold goodbye because we’re on your side!
Mold Inspections Prices
The Air Quality Test/Surface Swab costs $359 for homes/units up to 1600 square feet, which includes 1 exterior sample (used to establish a baseline) and 2 indoor samples. Every additional 800 square feet requires an additional sample (+$195). The mold assessor will determine the exact location. If mold has already been found, we will take 1 air sample and 1 surface swab to determine the type of mold and determine if it has spread out to the environment. We recommend reaching out to get an accurate estimate if you are scheduling for a multi-unit or 2-3 story buildings.
A Mold Assessment (or Water Damage Assessment), with Remediation Protocol (where applicable) costs $495 for homes/unita up to 1600 square feet. It includes air qality test/surface swab, a mold inspection, and infrared thermal imaging scan. If mold and/or water damage are found, a remediation protocol will be provided.
A Post Remediation Verification costs $350 for homes up to 1600 square feet. It includes testing and a clearance letter after the remediation has been completed.
Do I need a mold inspection?
Here at Elite Property Inspectors, we offer superior mold inspection services that always deliver. A baseline mold inspection is essential for maintaining a healthy, clean home with high indoor air quality, and it comes easy with us. Our mold inspection services bring invaluable benefits to homeowners.
Here are some of the most important reasons why you should consider scheduling our meticulous Elite Property Inspectors home and mold inspection service:
For homebuyers in Panama City who are concerned about mold when purchasing a new home. Mold testing offers peace of mind in such a big decision.
For verified mold assessment and verification of the need for remediation. Many insurance companies will not authorize mold remediation without demonstrated scientific testing.
To create the parameters for mold remediation. A testing company is usually consulted to help define the boundaries of an affected area for the remediators.
To identify the types of mold that are present in a home environment. Often residents are curious if a mold presence could relate to medical symptoms they may be experiencing.
To find “hidden mold” or mold growth that may not be visible within the home’s immediate visual structure, but may be a cause for concern as a result of water leakage or the development of a moldy odor.
In support of a legal case where objective scientific evidence is needed to support legal action.
Common Questions and Answers
Our professional mold inspectors at Elite Property Inspectors use a multistep process to determine whether there is any kind of mold hiding in your home. Our process typically includes:
Visual inspection and infrared scan. This is performed in each room to look for signs of microbial activity, water damage, moisture intrusion, dank odor, etc. Suspicious areas may require readings from a moisture meter or a thermal imaging camera to further detect moisture within wall cavities.
Air quality and/or surface swab. Based on the findings and history the inspector will identify which rooms require an air sample reading alongside an outdoor control sample to determine if elevated conditions exist. Further sampling and mold assessment may be recommended in order to determine the source of the problem and its spread.
The resulting report. A detailed report of your home inspection will come directly from the lab and include the types of molds found in your home, how your levels compare to “normal” levels, the glossary of mold, and a list of probable symptoms resulting from exposure. This is a legal and verifiable document.
The post-inspection process. Our certified mold professionals will guide you through this step. They will go over the report with you and offer advice on how to best move forward in the mold remediation process. The mold removal process should be handled expertly as it can be more dangerous than the mold’s initial presence.
To begin the mold inspection process, clients must first disclose their reasons or concerns for warranting the services of our certified mold inspectors. Our team will come at your convenience to conduct an exhaustive inspection of your property using a high-tech mold testing kit. Rest assured we never cut corners when checking for mold, but offer nothing but excellence to our clients!
How long does a mold inspection take?
In general, a mold inspection may last around an hour. However, exactly how long the inspection of your home will last will depend on a number of factors:
Whether the mold is visible or hidden
The size of your home
The afflicted area
As one of the most reputable mold inspection companies across the Panama City area, we deliver prompt, time-efficient services. Our team consists of the leading specialists in the field who boast excellent records, so they know exactly what and where to look. With us, you can count on stellar mold inspection and testing that won’t disrupt your daily life. Let’s bring back freshness to your home!
How do I prepare for a mold inspection?
After scheduling the services of experienced mold inspectors, you should take a few steps to prepare for your appointment:
Isolate the afflicted area by covering it with a plastic or sealing the room off by covering the door.
Don’t clean it yourself because you don’t have the necessary equipment and experience.
Make sure the pros can access the area with mold by clearing out any clutter or unnecessary items.
Book our mold inspection services in Panama City and let us handle the rest. We guarantee to be thorough and efficient, delivering our service to the highest industry standards. Our team members are InterNACHI-certified, so there’s no doubt they’ll do an above-par job. Reach out to us if you want to learn more about proper preparation before we come to your home for a professional inspection.
How can I prevent mold in my house?
By taking precautions and implementing best practices, you can prevent mold from growing and spreading in your home. However, if you discover any afflicted area, you may need to schedule professional mold removal and remediation services. Either way, here’s what you should keep in mind:
Address moisture issues. Familiarize yourself with the possibilities for direct water intrusion due to structural leakage, plumbing problems, or foundational issues. An excess of humidity can also lead to increased condensation and mold growth and development.
Keep your home clean. A well-kept indoor environment is instrumental in preventing mold growth. Wiping surfaces with household cleaners such as bleach, borax, or vinegar can be helpful in treating and killing mold and its spores. Remember to avoid mixing solutions before reading the safety instructions to avoid intoxication.
Ensure adequate airflow and ventilation. People often forget that an air conditioning unit also doubles as a building’s dehumidifier. Well circulated airflow and ventilation help prevent mold infestation risks by allowing water and condensation to escape. Remember to regularly check and clean your kitchen vent hood and HVAC filters.
Mind the dark. Mold loves to grow in dark damp areas, so avoid piles of wet laundry and open your blinds and shades regularly. Ultraviolet light kills mold.
However, keep in mind that mold remediation requires the intervention of licensed, trained professionals. So, we recommend you do not try to address the problem yourself, for your health and safety. Let us advise you on how to approach and resolve this problem!
Panama City, Florida #1 experts in home and mold inspection services
Here at Elite Property Inspectors, our team specializes in a range of home-related services, including expert mold inspection and prevention. We will check every nook and cranny of your home and suggest effective prevention and removal solutions.
Furthermore, we have the equipment and experience needed to detect even hidden mold in your home. Our qualified and seasoned specialists can also advise you on the best home maintenance practices that will help you prevent more serious damage or future problems. Bid mold goodbye because we’re on your side!

103 Palm Bay Blvd, Panama City Beach, FL 32408
Copyright© 2025 Elite Property Inspectors LLC - All Rights Reserved.
